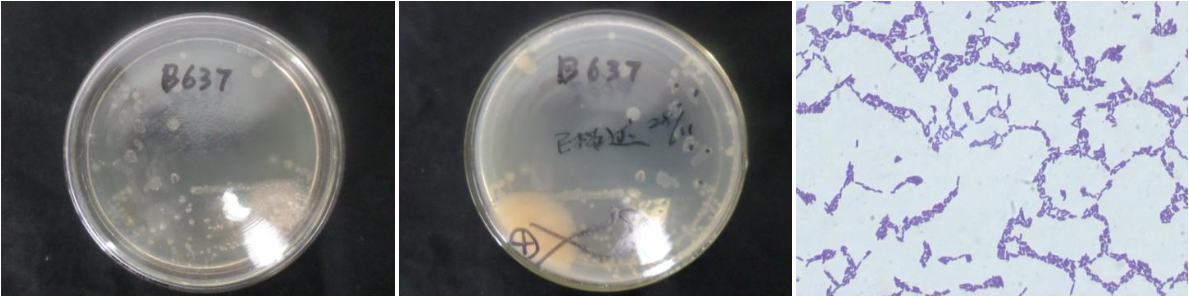

Loading...
| StrainNO | B637 |
| Classification | Arthrobacter |
| 16s rDNA sequence | CAAACTGGCGGCGTGCTATACATGCAAGTCGAGCGGAGATTTAAAAGCTTGCTTTTAAATTTTAGCGGCGGACGGGTGAGTAAC ACGTGGGCAACCTGCCTATGAGACTGGGATAACTCCGGGAAACCGGGGCTAATACCGGATAATTCTTTTCTACTCATGTAGAGA AGTTGAAAGATGGTTTCGGCTATCACTCATAGATGGGCCCGCGGCGCATTAGCTAGTTGGTGAGGTAACGGCTCACCAAGGCGA CGATGCGTAGCCGACCTGAGAGGGTGATCGGCCACACTGGGACTGAGACACGGCCCAGACTCCTACGGGAGGCAGCAGTAGGGA ATCTTCCGCAATGGACGAAAGTCTGACGGAGCAACGCCGCGTGAGTGATGAAGGTTTTCGGATCGTAAAACTCTGTTGTTAGGG AAGAACAAGTACCGGAGTAACTGCCGGTACCTTGACGGTACCTAACCAGAAAGCCACGGCTAACTACGTGCCAGCAGCCGCGGT AATACGTAGGTGGCAAGCGTTGTCCGGAATTATTGGGCGTAAAGCGCGCGCAGGTGGTCTCTTAAGTCTGATGTGAAAGCCCCC GGCTCAACCGGGGAGGGTCATTGGAAACTGGGAGACTTGAGTGCAGGAGAGAAGAGTGGAATTCCACGTGTAGCGGTGAAATGC GTAGAGATGTGGAGGAACACCAGTGGCGAAGGCGACTCTTTGGCCTGTAACTGACACTGAGGCGCGAAAGCGTGGGGAGCAAAC AGGATTAGATACCCTGGTAGTCCACGCCGTAAACGATGAGTGCTAAGTGTTAGAGGGTTTCCGCCCTTTAGTGCTGCAGCAAAC GCATTAAGCACTCCGCCTGGGGAGTACGGCCGCAAGGCTGAAACTCAAAGGAAT |
| Strain Morphology Photos | |
| Morphological Description | The morphology of Colony round;clam white;edge serrated;concentric-rings;central convexity;rugose;slippy;sticky;waxy;The morphology of strain:Rod;having spore with germinal mesophytic |